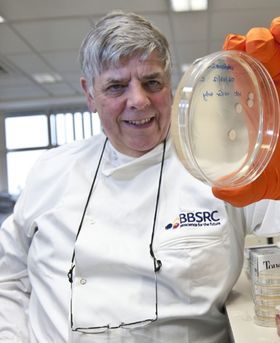
George Lomonossofft in a lab holding a petri dish.

Translational Microbiology Prize Winners
Find out more about what winning the Translational Microbiology Prize (formerly the Unilever Colworth Prize) meant to previous winners and more about their outstanding contributions to the discipline of microbiology.
Translational Microbiology Prize (formerly the Unilever Colworth Prize) Winners
2025
Professor David Aanensen
University of Oxford, UK
Translating insight: linking genomics and epidemiology for public health
“It is a great honour to receive the microbiology prize on behalf of my team and our collaborators, both past and present, whose passion and insight have translated genomic and microbiological insight into impactful global public health policy and practice, and who have made the journey so enjoyable.”

2024
Professor Catherine Rees
University of Nottingham, UK
The challenge of developing phage-based assay to detect Mycobacteria - lessons learned on a journey from cattle to humans
“I am delighted to have been awarded the Translational Microbiology Prize by the Microbiology Society. The Actiphage project represents years of endeavour by a large number of talented scientists who have passed through my lab and who have contributed to the success of this project in different ways. Thank you all - and thank you to the Society for dedicating a prize recognising the value of translational research which is often overlooked.”

2023
Professor Ravindra Gupta
University of Cambridge, UK
SARS-CoV-2 variants and vaccines
“It’s a huge honour to receive this Prize, especially looking at the other individuals who have been awarded this in the past who are impressive leaders in their field…These are awards to one person, but actually they represent groups of people we’ve worked with, my team members.”

2022
Professor Paul Griffiths
(University College London, UK
Cytomegalovirus: direct and indirect clinical effects and prospects for control by immunisation
“I am surprised, delighted, and honoured to receive the Microbiology Society Prize Medal. I am grateful to and proud of the many scientists who have come through my lab to go on this scientific adventure with me! It has been a privilege and thrilling to work with the team as they try to change the perception of bacteria from being thought of as asocial loners to being considered sophisticated interacting organisms that, by acting as collectives, can have a profound influence on nature, health, and disease. The Microbiology Society Prize Medal is a spectacular recognition of my lab team’s creativity, tenacity, and belief that bacteria still house many important mysteries and so they are worthy of us devoting our professional lives to exploring them.”

2021
Professor Azra Ghani
Imperial College London, UK
Getting back on track: the tools and strategies needed to achieve malaria elimination and eradication
"I am delighted to receive this award from the Microbiology Society. Particular thanks go to all the former and current staff and students with whom I have had the pleasure of working and who have managed to juggle the underpinning science alongside the translation of our work into policy-relevant outputs – not least during the current COVID-19 pandemic. I am also grateful to colleagues in the international malaria community in academia, industry and public health agencies for their continued engagement, support and enthusiasm as we work together to end malaria.”
Image credit: Mark Henley, WHO, 2017

2020
Professor Manu Prakash
Stanford University, USA
Frugal science: a practical guide to making science accessible to all
“I am truly humbled and inspired to be accepting this award. Our work to share scientific tools and democratize access to science is only possible due to the passionate foldscope users that bring frugal science tools to communities far and wide. I also want to acknowledge the tireless efforts of every one in the foldscope team, and all my former and current students who make science fun every day.”

2018
Professor Sharon Peacock
University of Cambridge, UK
Translating findings from bacterial whole genome sequencing into clinical practice and public health policy
“I am thrilled to win this prestigious prize, which reflects the immense hard work and dedication of my outstanding research group over the last 10 years. I am grateful to each of them, who are all as passionate as I am about the work they do and have a shared purpose to translate a technology that will improve the quality and impact of diagnostic and public health microbiology. A big thank you!"

2017
Professor Martin Ryan
University of St Andrews, UK
The 2A protein co-expression system: a lesson learnt from viruses to make therapeutic proteins, transgenic plants and animals, cures for cancer and pluripotent stem cells
“It’s gratifying, because all the work that people have done in my lab throughout the years has been recognised. We know the work is valuable via citation numbers, but it’s a thrill for me personally because it shows the contribution is well regarded by others.”

2016
Professor Gurdyal Besra FRS
University of Birmingham, UK
The mycobacterial cell wall: assembly and new drug targets
“People who know me know that I’m very modest and don’t like to play up what I do – I’ve always looked at it as just going to work and not doing anything special compared to what anyone else is. When you receive a prize you feel a great sense of value in having others in the research community recognise what you do in a wider context.”

2015
Professor George Lomonossoff
John Innes Centre, UK
Turning diseases to commodity: working on a plant virus for fun and profit
“There’s nothing better than being recognised by your peers. There are times as scientists that we tend to doubt whether what we do is important, so getting recognition of my work – and the work of my group – is very important. I’m representing a lot of people who have done a lot of work over the years.”
2013
Professor Jeffrey Almond
OSIVAX, France
Vaccines R&D: challenges for the 21st century
Image credit: Jeffrey Almond

2011
Professor George Salmond
University of Cambridge, UK
Bacterial Sociology: Quorum Sensing, Virulence, Antibiotics and Survival
Image credit: iStock/Rost-9D

2009
Professor Geoff Gadd
University of Dundee, UK
Metals, Minerals and Microbes: Geomicrobiology and Bioremediation
Image credit: iStock/photosbyjim

2007
Professor Paul Williams
University of Nottingham, UK
Look Who's Talking: Communication and Co-operation in the Bacterial World
Image credit: iStock/3dalia

2005
Professor Rick Titball
University of Exeter, UK
Gas Gangrene, an Open and Closed Case
Image credit: iStock/Dr_Microbe

2003
Professor Thomas Humphrey
Swansea University, UK
Oh for an 'Ome of My Own'. Salmonella and Campylobacter as Zoonotic Pathogens
Image credit: iStock/urfinguss

2001
Professor Philip Marsh
University of Leeds, UK
Are Dental Diseases Examples of Ecological Catastrophes?
Image credit: iStock/Dr_Microbe

1999
Professor Lynne Macaskie
University of Birmingham, UK
Applications of Micro-organisms to Heavy Metals and Nuclear Wastes Decontamination
Image credit: iStock/kirstypargeter

1997
Professor Graham Stewart
UNiversity of Surrey, UK
Challenging Food Microbiology from a Molecular Perspective
Image credit: iStock/anusorn nakdee

1995
Professor Mervyn Bibb FRS
John Innes Centre, UK
Understanding and manipulating antibiotic production in Streptomyces
Image credit: iStock/ClaudioVentrella

1993
Professor Gordon Dougan FRS
University of Cambridge, UK
Microbial Pathogens as Probes of the Mucosal Immune System
Image credit: Gordon Dougan

1991
Dr Philip Minor
National Institute for Biological Standards and Control, UK
The Molecular Biology of Polio Vaccines
Image credit: Nicola Stonehouse and Oluwapelumi Adeyemi

1989
Professor Geoffrey Yarranton
Humanigen, USA
Efficient Expression of Heterologous Genes in Prokaryotic and Eukaryotic Cells
Image credit: iStock/selvanegra

1991–2000
A new location and modernising Microbiology
The continued growth of the Society and its affairs meant that the Society headquarters, at Harvest House, had become too small. In 1991, the Society purchased Marlborough House, in a village seven kilometres south of Reading town centre.
In 1994, the Journal of General Microbiology was relaunched with a modernised format, and it’s title was changed to Microbiology. On-screen editing was introduced in the Editorial Office in the mid-1990s.
Image: Branding used for the journal of Microbiology today.
Image credit: iStock/ClaudioVentrella

